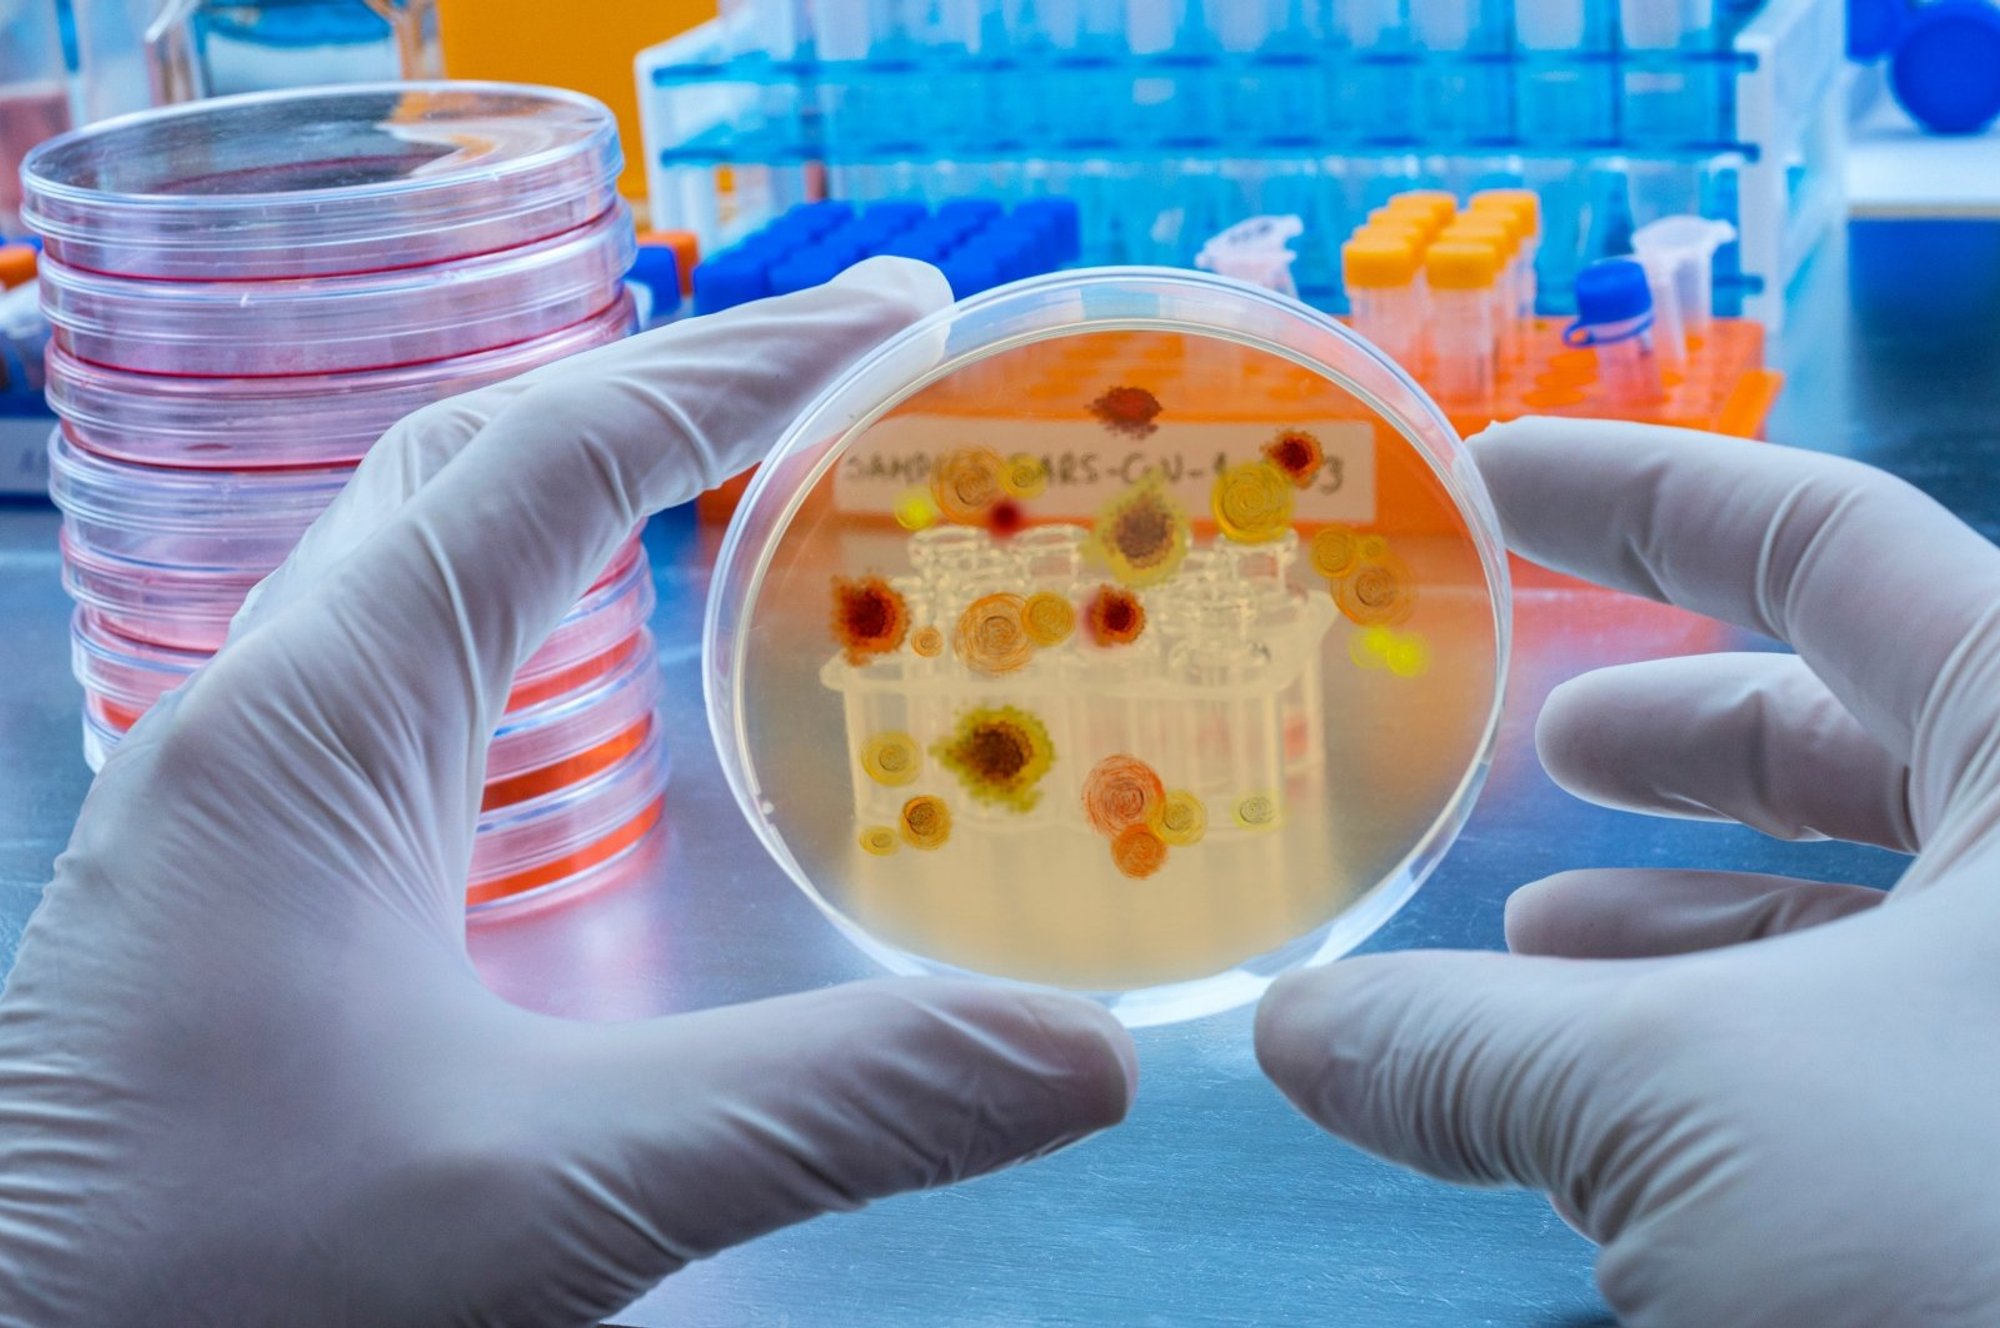

I følge WHO-data ble det i 2021 registrert 247 millioner tilfeller av malaria, hvorav omtrent 600 000 endte med døden. Malaria kan pådras når du reiser til over 100 land. Denne sykdommen er utbredt i tropiske og subtropiske regioner: Afrika, Asia, Latin-Amerika. 95 prosent av alle sykdommer og dødsfall registrert i den afrikanske regionen. Mer enn halvparten av dem er i Nigeria, Den demokratiske republikken Kongo, Niger og Tanzania.
«Tilfeller av importert malaria forekommer hvert år i Litauen. Årsaken til infeksjonen er uregelmessig bruk eller ikke-bruk av antimalariamedisiner før eller under reise, samt utilstrekkelig personlig beskyttelse mot mygg,» bemerker rapporten.
2012-2022 ble det registrert 58 tilfeller av malaria. Tre pasienter med tropisk malaria døde. De fleste av de som ble syke besøkte land på det afrikanske kontinentet for arbeid eller utdanning.
Malaria er en parasittisk blodsykdom som overføres ved bitt. Anopheles hos hunnmyggen av slekten og viser seg ved regelmessig tilbakevendende feberanfall.
NVSC-spesialister minner om at når du planlegger utenlandsreiser, er det nødvendig å forberede seg ansvarlig.
«Spør om landet er endemisk for malaria. Dette kan gjøres ved å besøke NVSC-nettstedet og velge landet du ønsker å reise til. Hvis malaria rapporteres å være vanlig i landet du skal reise til, ta kontakt med fastlegen din for å få medisiner mot malaria, heter det i uttalelsen.
NVSC anbefaler beskyttelse mot myggstikk. Når du besøker områder som er rammet av malaria, er det nødvendig å bruke klær som dekker hender og føtter, bruke myggmidler for å beskytte ansiktet og kroppsdeler som ikke er dekket av klær, dekke dører og vinduer i rom med myggnett (spesielt om natten) ), velg himmelsenger for natten. Mygg angriper mest ved solnedgang og soloppgang, så det anbefales å være i lukkede rom beskyttet mot inntrengning av mygg.
Under turen anbefaler spesialister å nøye overvåke helsen din, og hvis symptomer (frysninger, feber, hodepine, muskelsmerter, svakhet) vises, bør du umiddelbart konsultere en lege på et behandlingssenter. Når du kommer tilbake fra en tur, anbefales det å informere fastlegen om besøket i et område med risiko for malaria, selv om du har tatt antimalariamedisiner.
Selv om malaria for tiden er et av de mest presserende folkehelseproblemene i verden, forventes det å bli effektivt kontrollert i fremtiden. En malariavaksine for 6 uker til 17 måneder er for tiden autorisert av European Medicines Agency. for vaksinering av spedbarn i endemiske områder. Denne vaksinen vil beskytte ikke bare mot tropisk malaria, men også mot hepatitt B.

«Extreme zombie guru. Avid web lover. Passionate beer fanatic. Subtly charming organizer. Typical coffee ninja.»